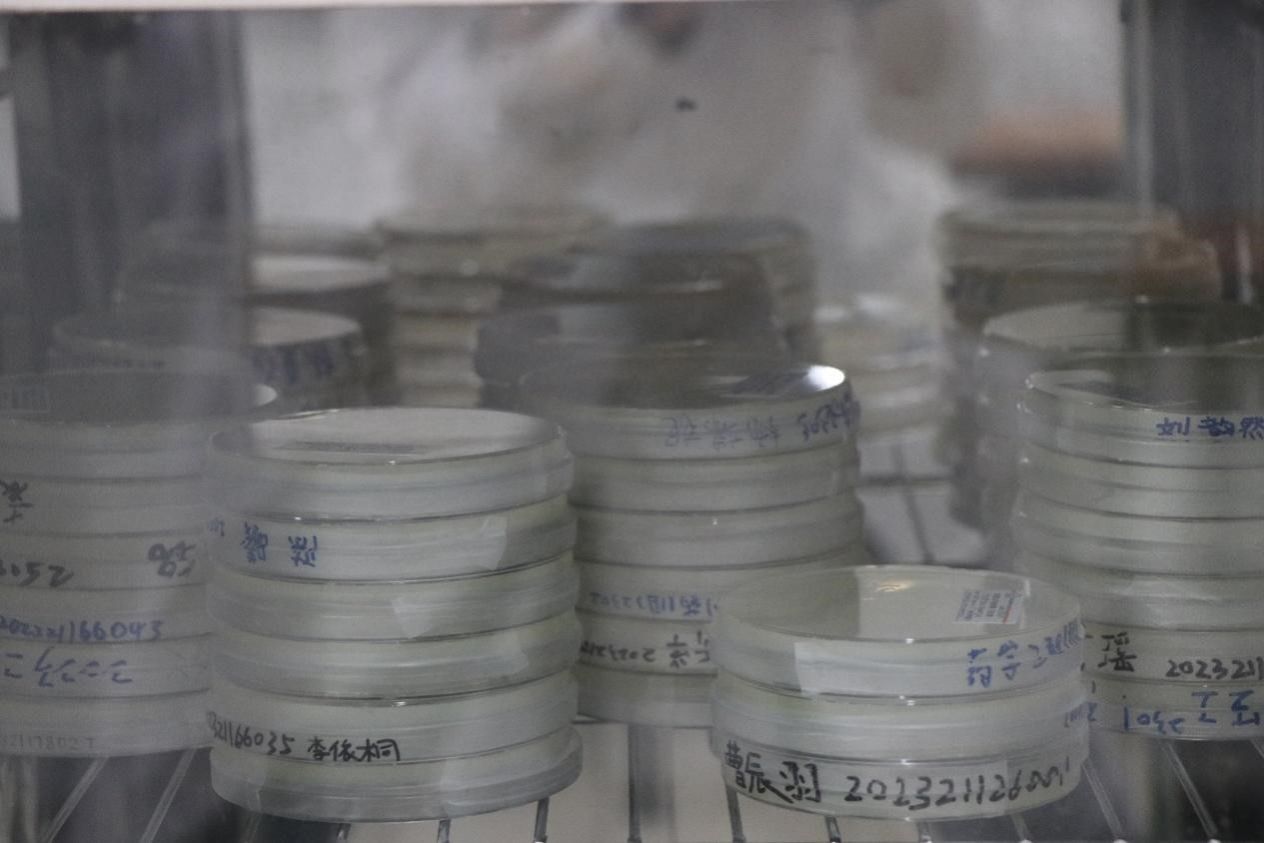

菌为翰墨绘世间,皿为宣纸载天地。2023年11月18日,由万博体育bet 生物与制药工程学院和生物化学工程国家级实验教学示范中心(万博体育bet )举办的“皿”上添花活动顺利开展,韦策老师担任技术指导。
实验台桌面上、酒精灯火焰旁,在学生会科创创新部工作人员的指导与带领下,选手们用接种环与各色菌液有序完成了在培养皿上作画的操作。活动结束,工作人员将参赛选手的作品逐一放入恒温培养箱,待菌落生长完全,一个个培养皿上呈现生动有趣的画作。
本次活动作为生工学院的特色主题活动,旨在提高学生的实验操作和动手实践的能力,让同学们以新奇有趣的方式接触实验的相关操作。该活动以“寓教于乐”的方式将微生物专业实践技能与美育教育相结合,有效提升了同学们的动手能力与实践精神,促进同学们德智体美劳全面发展。
图文:胡蓝馨,贺鑫;单位:生工学院;审核:徐元龙,贾红华